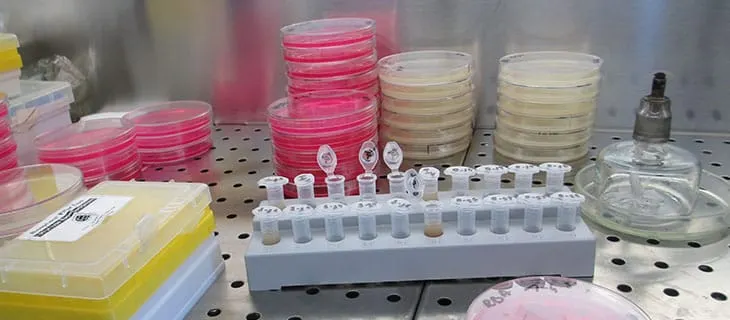
Putting patients first and encouraging innovation

Jeff Ansell
CHICAGO — A new era has begun at IRI. Already a leading provider of big data, predictive analytics and insights that help clients grow their business, the company is now in an even better position to have an impact on the marketplace as a result of a new financial structure.
Last month, IRI closed a deal with New Mountain Capital and Vestar Capital Partners through which Vestar will take a substantial stake in IRI, with the two investment firms jointly governing the company. Jeffrey Ansell, a senior advisor at Vestar and IRI board member since 2011, will serve as chairman of IRI. New Mountain and other existing investors are retaining a meaningful stake in the company, according to the agreement, terms of which were not disclosed.
The IRI management team is led by chief executive officer Andrew Appel, who has a track record of partnering with clients to leverage data, technology and cutting-edge ideas to help achieve better business results, according to Ansell. “Working with Andrew and this talented management team, as well as with New Mountain and Vestar, we can continue to realize the strong client impact and value creation potential of this business,” Ansell says.
Since New Mountain became involved, IRI has transformed its business through significant investments in leading-edge technology and built a partner network of more than 100 companies, notes Appel, adding that Vestar will only serve to enhance IRI’s standing. “We’re excited about the new relationship with Vestar, which will further strengthen IRI’s ability to provide superior client service, particularly given Vestar’s experience in consumer goods, data and information technology. With the additional support, IRI will have even more resources at our disposal to help clients deliver profitable revenue growth,” he says.

Andrew Appel
Under Appel’s leadership, IRI has made a series of moves that have made it an even more desirable target for investors such as Vestar and New Mountain. First, there was a general philosophy, which Appel refers to as “growth delivered,” which meant moving IRI and the industry from “concepts of insights, developing a view on what had occurred, historical analytics, an analysis on what was driving changes in performance, to a set of recommended actions off of data and technology that would drive differential growth for its clients.
On the business side, IRI decided to invest in four areas, according to Appel — technology, retail, media and new markets. “We made a big bet on technology, and it was under the auspices that all information needed to be on demand with dislocated visualization and sophisticated analytics that would drive growth,” Appel says. “I remember saying, ‘When was the last time you printed out Google?’ Why is it that it takes two minutes to run a report, you copy it to PowerPoint, email it around. Everything is ultimately going to be mobile, real time on demand.”
Sophisticated visualization, Appel says, was like a tableau or micro strategy, but today it is more about prescriptive analytics and predictive models to drive automated insights and augmented decision making; drive decisions in the hands of people to make them better, faster decision makers; and ultimately automate decisions altogether.
IRI also gambled on retail by working with retailers to use data and information to drive the performance of their business as well as enhance collaboration — “automate, enhance, put in sophisticated technology and data analytics tools to enhance a collaboration between manufacturers and retailers.” Initially, Appel says IRI threw the dice on retail in order to support its CPG business. “It was the fact that our platform had some unique characteristics that actually were more differentiating for a retailer than even a manufacturer because retailers have hundreds of thousands of items and manufacturers have thousands,” explains Appel, adding that IRI’s technology allows clients to get on-demand analytics across an infinite number of products and dimensions to keep it simple.
In terms of media, IRI’s view was a simple one, Appel notes, that being to buy advertising on the impact it has on a consumer behavior or purchase versus how many people saw the ad. “What if I could sell you $10 million of sales versus $1 million of advertising? Which would you buy?” Appel says, adding that it would be better to buy the certainty of outcome, and, given IRI’s history of understanding what drives purchase behavior, Appel believed IRI could create an entirely new way to buy advertising in what is a $50 billion industry in the U.S. — and one that was moving very quickly to traceable digital advertising.
In 2014, IRI ventured into a new market with the acquisition of Aztec, which was the company’s largest acquisition and substantially expanded IRI’s geographic footprint as well as slowly expanding IRI’s industry footprint through licensing its software and other industries.
IRI’s focus on these four areas has paid dividends. “We’re growing significantly higher in terms of our top-line growth rate,” Appel says. “We’ve done a very nice job of improving profitability while at the same time investing over $500 million in the platform.”
This success and focus, along with Appel’s leadership, is in large part why Ansell says Vestar wanted to throw in with IRI, noting that the company’s Liquid Data technology provides unprecedented speed of data availability, analytical capability and visualization tools while the unique retailer relationships give an incredible view into purchasers, particularly through access to shopper and loyalty card information. This information is critical, Ansell says, as it provides a much better line of sight into the effectiveness and efficiency of advertising, which is the cornerstone of advertising in today’s industry. “Nobody has more money to spend,” Ansell says. “You can’t outspend your competition. You have to outsmart them.”
These factors, combined with Appel’s leadership, explain IRI’s double-digit top- and bottom-line growth — and these competitive advantages are not advantages that can be easily neutralized. “Having been on the board for seven years, it took a number of years of hard work and $500 million of investment, a half a billion dollars in the Liquid Data technology to be able to create this competitive advantage,” Ansell says. “And it’s not one that’s going to be quickly neutralized, no matter how hard somebody tries. And, of course, Andrew’s team has a lot of innovation under way in order to be able to stay one step ahead. These are all the reasons why it became increasingly exciting for Vestar, and they just couldn’t be more excited about being a part of the company.”
With all that IRI has accomplished and with the excitement generated from the partnerships with New Mountain and Vestar, there’s still much more to be done at IRI, and Appel is optimistic about the future.
The strategic opportunity Appel sees for IRI in the next five years or so is for the company to reinvent itself — as well as the industry — from providing charts and an analysis to institutionalizing the use of data and analytics in the minute-to-minute, day-to-day decision making of companies.
“You’ve got to get out of the business of chart production and sitting at the end of your email waiting for an executive to ask a question,” he says. “You’ve got to democratize and automate that part of the business. We have a bunch of great opportunities to find new CPG clients, because there is a lot of change going on in our industry.”
In an industry that is constantly changing and evolving, Appel sees opportunity as companies recognize the competitive advantage to be had in reaching out to IRI to get a better understanding of how they can work with the company on a deeper and more thorough basis.
The growing importance and influence of e-commerce is another area of opportunity for IRI, according to Appel, who believes IRI’s insights can help companies succeed and win in the e-commerce space.
IRI has partnerships with all the major e-commerce providers, from Amazon and Walmart on down. “We are the only market research firm right now that has an e-commerce solution that’s been in the market for three years,” Appel says.
While IRI has historically been a data provider, the company has now moved beyond that profile to also provide actionable insights to help interpret data, which serves clients — be they retail or CPG. In essence, IRI not only can formulate the data a company needs but can offer practical suggestions and advice from that data on how that company can grow its business.